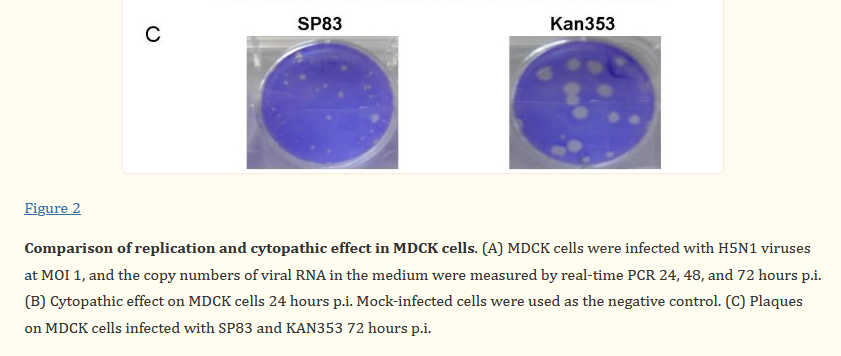
Joe Hendry tweet media

Joe Hendry
169 posts

@PChandr43659403 @BoyScou84038220 @Burki677 @sense_strand @Censored4sure @ThroneOfCrypto @TakethatCt @dan_gadd @ValZimmer2 @PenOfAPisces @fortinbras @claushetting @deal_jeanine @ViroLIEgy @wallischris10 @hauxton @tonymac5 @sunshine_toes @rubrogram @dirk_fasshauer @Bio_inspiration @JimHB_4Liberty @lifestylemanoz @JamieAA_Again @DdkDav @kamziknahorach @SwaledaleMutton @The_Seeadler @KStateTurk @JJJJenniferrrr2 @lagerth13136056 @Dirk_aus_Hessen @bitcoinbumBB @SoupTomatoSoup @DrCrazynski @THC1001 @adiosmuchachos4 @Debunk_the_Funk @rw_christian @richdatasci @themcpaw @HealthcareGlob1 @DarrenT76334333 @ExposeThePlan @TrevorJukes1 @RameseSanders @macgyvertang20 @DAVID__BB @ine16840704 @JoeHendry696 "virus" IS a hypothesis.











